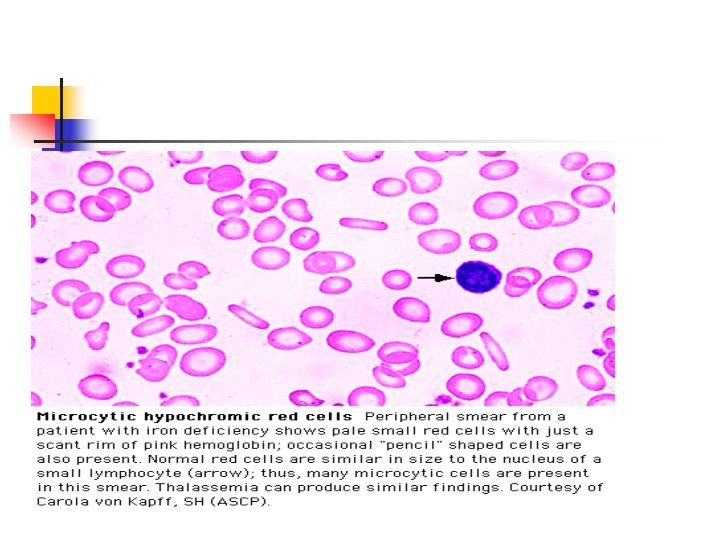
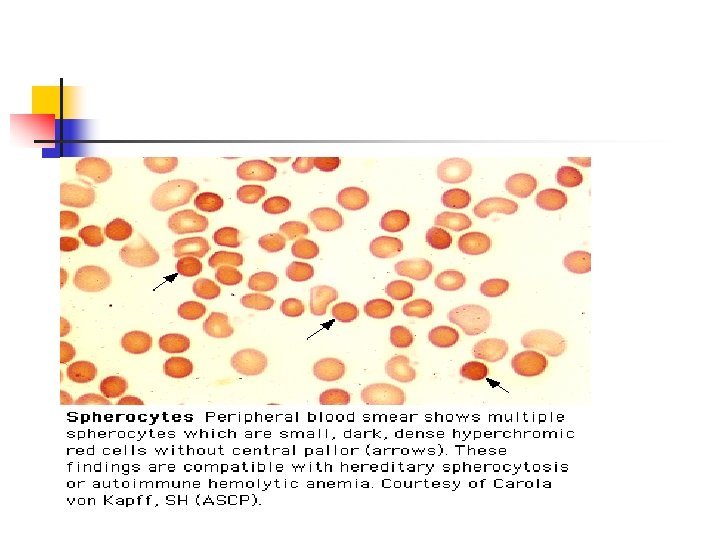
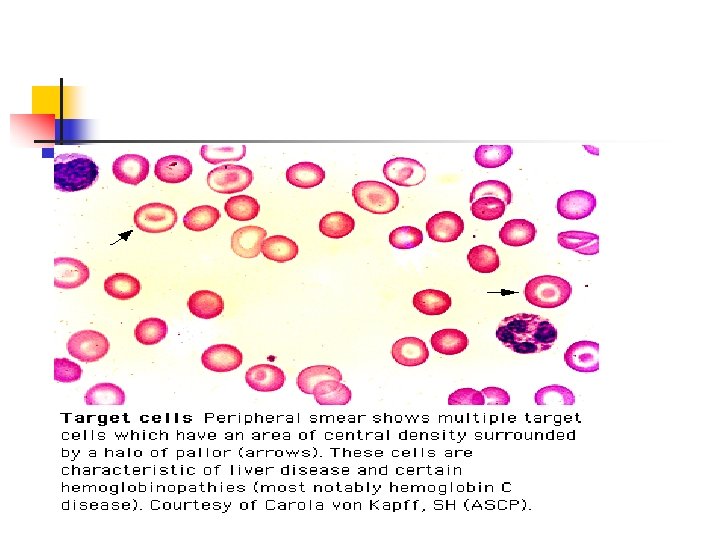

ANEML OCUA YAKLAIM PROF DR AYA VTRNEL YEDTEPE

- Slides: 57
ANEMİLİ ÇOCUĞA YAKLAŞIM PROF. DR. AYÇA VİTRİNEL YEDİTEPE ÜNİVERSİTESİ TIP FAKÜLTESİ
ANEMİ n n Eritrosit kütlesinin veya kan hemoglobin konsantrasyonunun azalması olarak tanımlanır. Pratikte Hemoglobin (Hb) ve hematokrit (Hct) değerlerinin azalması olarak görülür.
n Anemili bir çocuğun değerlendirilmesi yaşa göre saptanmış Hb ve Hct değerlerine göre yapılmalıdır.
ERİTROPOEZ n n n Fetal eritropoez megaloblastik olarak başlar, bu hücreler yaklaşık 4 -5. gestasyon haftasında yolk sac’da görülür. Normoblastik eritopoeze geçiş yaklaşık 6. gestasyon haftasında oluşur. Bu dönemde kan yapımı ve kayar karaciğer 3. aydan 6. aya kadar hematopoezin başlıca organıdır. Sonra yerini kemik iliğine bırakmaya başlar.
n n n 3. gestasyon ayında hematopez dalakta, timus ve lenf nodlarında da başlar. Karaciğer ve dalak doğumdan sonraki ilk haftaya kadar kan hücrelerini üretmeye devam eder. Fetal eritropezi de eritropoietin hormonu düzenler
n n n Kemik iliği eritropoezi 4. gestasyon ayında ortaya çıkar ve artarak devam eder. Kemik iliği selülaritesi 30. haftada maksimuma ulaşır. Doğumdan sonra ilik daha da genişler, tüm aksiyel iskeleti, uzun kemikleri ve yassı kemiklerin çoğunu doldurur. Intrauterin dönemde eritropoez fetal kontrol altındadır. Maternal faktörlerden çok az etkilenir.
n n Gelişim dönemine göre sırası ile embriyonik, fetal ve erişkin tipi hemoglobinler sentezlenir. 12. haftadan 34. haftaya kadar total hemoglobinin %90 -95’i Hemoglobin F’tir. Doğuma kadar haftada %3 -4 azalarak %70 -75’e iner.
n n Gebelik boyunca sentezlenen Hb. A, doğumda hemoglobinin geri kalan kısmını oluşturur ve doğumdan sonra giderek artar. Doğumdan sonra da Hb. F düzeyi düşmeye devam ederek 6 -12. aylarda erişkin normali olan %2’nin altına iner.
n n Eritropoez doğumdan sonra ilk birkaç günde ¹/2 - ¹/3 e, ilk haftada ise ¹ /10 a iner. 6 -8 hafta kadar süren bu azalma doğumda oluşan doku oksijen düzeyinde artma ve eritropoetin düzeyinde düşme sonucunda meydana gelir.
n n Erişkinde 120 gün olan eritrosit yaşam süresi yenidoğanlarda 90 gün olduğu için bu dönemde eritrosit yıkımı da devam etmekte ve büyüme nedeniyle kan volümündeki artış da hemodilüsyona benzer şekilde kan sayımlarına etki eder. Bir taraftan yapım azalması bir taraftan yıkım artışı ve büyüme ile Hb düzeyi ilk haftadan sonra giderek azalır ve 8 -12 haftalarda 9 gr/dl’ye kadar iner = SÜT ÇOCUĞU FİZYOLOJİK ANEMİSİ
n n Physiologic anemia occurs at 8 to 12 weeks in full-term infants and at 6 to 8 weeks in premature infants. Full-term infants may exhibit hemoglobin levels as low as 9 g/d. L at this time, and very premature infants may have levels as low as 7 g/d. L
ANEMİLERİN SINIFLANDIRILMASI n Fizyolojik Sınıflandırma n Morfolojik Sınıflandırma
FİZYOLOJİK SINIFLANDIRMA ETYOLOJİLERİNE GÖRE SINIFLAMA n n n Eritrosit Yapım Bozukluğu Hızlı eritrosit yıkımı = hemoliz Eritrosit kaybı = kanama
ERİTROSİT YAPIM BOZUKLUĞU n n n n Demir eksikliği Vit B 12 ve folik asit eksikliği Vit B 6 eksikliği Kemik iliği yetersizliği – Saf eritrositer anemi =Blackfan Diamond – Aplastik anemi – konjenital= Fanconi – edinsel – Diseritropoetik anemi – İnfiltratif hastalıklar İnfeksiyon Böbrek ve Karaciğer hastalıkları Bağ dokusu hastalıkları
ERİTROSİT YIKIM ARTIŞI 1) 2) Eritrosit içi nedenler – Membran defektleri = Herediter sferositoz, stomatozis, akantositozis, eliptositozis – Enzim defektleri = GGPD, Piruvatkinaz eksikliği – Hb defektleri = Talasemiler, orak hücreli anemi Eritosit dışı nedenler – İmmun hemolitik anemiler – isoimmun – otoimmun – Non immun hemolitik anemiler = infeksiyonlar, ilaçlar, kollajen doku hastalıkları, mikroanjiopatik hemolitik anemi
FİZYOLOJİK SINIFLAMA RETİKULOSİT SAYISI DEĞERLENDİRİLMESİ n n Artmış retikülosit _ devam eden hemoliz , kan kaybı Düşük retikülosit sayısı _ Azalmış eritrosit yapımı _ Kemik iliği depresyonu
MORFOLOJİK SINIFLAMA n MCV (Ortalama eritrosit hacmi=OEH) n MCH (Ortalama eritrosit hemoglobini=OEHb ) n MCHC(Ortalama eritrosit hemoglobin konsantrasyonu= OEHb. K) * Lökosit ve trombosit değerleri de aneminin nedenlerini ortaya koymaya yardım eder.
MCV n Otomatik kan sayımı cihazları tarafından ölçülür ve fentolitre birimi olarak değerlendirilir. n Mikrositik, normositik, makrositik n Yaşa göre değişiklikler gösterir
MCV n Retikülositler matür hücrelerden daha büyük MCV’ye sahip olduklarından artmış retikülosit sayısı olan hastaların diğer eritrositleri normositik olmasına rağmen MCV’leri yüksek olabilir.
n n 70 + (age in years). This number (in mm 3) approximates the lower limit of MCV in children younger than 8 years old, below which microcytosis is present. From 8 to 12 years, the lower limit for normal MCV is 77 mm 3, and from 12 to 18 years, it is 78 mm 3
n MCV < 70 fl – Demir eksikliği – Kurşun zehirlenmesi – Kronik hastalıklar – Thalasamiler – Hemoglobinopatiler – Sideroblastik anemiler n MCV >100 fl – – – – – B 12, folat eksikliği Yenidoğanlar Hipotiroidizm Karaciğer hastalıkları Splenektomi sonrası Myelodisplastik sendrom Aplastik anemi Diseritropoetik anemi Down sendromu n MCV 70 -100 gl – – – Diamand Blac İnfeksiyon İlaçlar Böbrek hastalıkları Akut kan kaybı Lösemi Aplastik anemi Membran defektleri Enzim eksiklikleri Hemoglobinopatiler Otoimmun hemolitik anemi
MCHC n 100 ml eritrosit başına düşen gr Hb olarak ifade edilir. n 33 -34 gr/dl n Bu değerlerin altı hipokromiyi gösterir.
ÖYKÜ ve FİZİK MUAYENE SEMPTOMLARIN AĞIRLIĞI ve BAŞLAMA ZAMANI Semptomların başlama zamanı ve ilişkili olduğu durumlar n Doğum öyküsü n Yenidoğan dönemi öyküsü n Aile öyküsü * Daha önce saptanmış anemi, kalıtsal; ilk defa ortaya çıkan anemi, akİz etyolojiyi düşündürür. n
SEMPTOMLAR n n n n Letarji Taşikardi Solukluk Halsizlik İştahsızlık Egzersiz sonrası dispne Sarılık Kronik anemili bir hasta, aynı Hb değerine sahip akut anemili bir hasta kadar semptomatik olmayabilir.
SEMPTOMLAR BULGULAR Daha önce hemolitik epizod varlığı n İdrar renginde değişiklik n Gözlerde sararma n Anemi semptomları ile ortaya çıkan sarılık
Gastrointestinal yoldan kanama varlığı n Barsak hareketleri n Kabızlık- İshal
Adet gören kızlarda n Menstürasyon süresi n Kanama miktarı ve sıklığı
Geçirilen hastalıklar n Kronik hastalıklar n İnflamatuvar durumlar n İnfeksiyonlar * Hb değeri aktif infeksiyon sırasında 11, 5 gr/dl düşme gösterebilir.
Toksin veya İlaçlar n Alınan İlaçlar ve nitrat içeren suların sorulması n Oksidana bağlı hemoliz öyküsü n Homeopatik /bitkisel bazı ilaçların kullanımı, kurşun ile temas, boyaya maruz kalma
Diet n n n Dietteki demir, folik asit, B 12 içeriği ve miktarı Anne sütü alma süresi Ek gıdalara başlama zamanı İnek sütü miktarı Pika öyküsü
DOĞUM ve NEONATAL ÖYKÜ n n Kan grupları Kan değişimi Gestasyon yaşı (Demir eksikliği ve E vit eksikliği) Yenidoğan hiperbilirubinemisi, fototerapi, kan değişimi oyküsü (herediter hemolitik anemi)
AİLE ÖYKÜSÜ, IRK VE ETNİK KÖKEN Sarılık, safra kesesi taşı, splenomegalisi olan aile bireyi n Kolesistektomi, splenektomi geçiren aile bireyi n Irk ve etnik köken – Hemoglobinopati, enzim defektleri ( Thalasemi, Akdeniz, Güneydoğu Asya, Hb. S, C, siyah ırk) n
FİZİK MUAYENE’de n Deri n Gözler n Ağız n Yüz n Eller n Abdomen
Solukluk n Konjonktiva n Tırnak yatakları n Avuç içi Saptanır.
Hemoliz yaşayan çocukta n Sarılık n Splenomegali
LABORATUVAR İNCELEMELERİ n Tam kan sayımı n Retikülosit sayısı n Periferik yayma Daha sonra kesin ve sonuca götüren çalışmalar yapılır. *Kapiller kan örneklerinde Hb ve Htc değerleri venöz kan örneğine göre daha yüksek çıkabilir, sınırda değerler atlanabilir.
TAM KAN SAYIMI n Otomatik kan sayma cihazlarında: Hb RBC direkt ölçülebilen değerler MCV Htc MCHC hesaplanan değerler RDW WBC Platelet MPV
RDW= Redcell distrubition width Eritrosit dağılım genişliği Eritrosit büyüklüğü değişkenliğinin kantitatif ölçüsü= ANİZOSITOZİS’i gösterir. MCV’nin bir foksiyonu olması nedeniyle normal değerler yaşa göre hafif değişkenlik gösterir ve genellikle %12 -14 arasındadır. Mikrositer anemisi olan çocukta demir eksikliği ile thalasemi ayrıca tanısında yardımcıdır. *RDW > 20 demir eksikliğini düşündürürken normal RDW thalasemiyi düşündürür.
MENTZER İNDEX MCV RBC < 13 Thalasemi > 14 Fe eksikliği anemisi
RETİKULOSİT Kemik iliğindeki eritopoetik aktiviteyi gösterir. Düzeltilmiş retikülosit = Ret x hasta Htc normal Htc
Anemi + retikülositoz n Hemoliz n Akut kan kaybı n Demir, folik asit ile replasman tedavisine yanıt
Anemi + retikülositopeni n Aplazi n Malign hücre ile infiltrasyon n İnfeksiyon n Toksik ajanlarla depresyon n Yetersiz eritropetin yapımı
PERİFERİK YAYMA n n n Normal eritrosit çapı= küçük lenfosit çekirdek çapı ( mikrositoz, makrositoz ayırımında önemli) Bikonkav disk şeklinde olan matür eritrosit merkezindeki solukluk çapın 1/3 ü kadardır. (Artışı hipokromi-Demir eksikliği, thalasemi) Sferositlerde ve retikülositlerde merkezi solukluk yoktur.
Normal periferik yayma
n n RBC targets on a peripheral smear are caused by excessive membrane relative to the amount of hemoglobin. Therefore, target cells are found when the membrane is increased (e. g. , in patients with liver disease) or when the intracellular hemoglobin is diminished (e. g. , in patients with iron deficiency or thalassemia trait). Target cells may also be found in patients with certain hemoglobinopathies (e. g. , hemoglobins C and SC). In these instances, the target cells are caused by aggregation of the abnormal hemoglobin
n Howell-Jolly bodies are nuclear remnants that are found in the RBCs of patients with reduced or absent splenic function and in patients with megaloblastic anemias. They are occasionally present in the RBCs of premature infants n . Howell-Jolly bodies are dense, dark, and perfectly round, and their characteristic appearance makes them easily distinguishable from other RBC inclusions and from platelets overlying red cells.
n n Heinz bodies represent precipitated denatured hemoglobin in the RBC. Heinz bodies occur when the hemoglobin is intrinsically unstable (e. g. , as in hemoglobin Koln) or when the enzymes that normally protect hemoglobin from oxidative denaturation are abnormal or deficient (e. g. , as in G 6 PD deficiency). These inclusions are not visible with a routine Wright-Giemsa stain but can be seen readily with methyl violet or brilliant cresyl blue stains.
LÖKOSİT ve TROMBOSİT Lökopeni/ nötropeni ve/ veya trombositopeni + ANEMİ Kemik iliği fonksiyonu normal değil n İlaç/ toksin ile kemik iliği depresyonu n Folik asit/ B 12 eksikliğine bağlı kemik iliği hipoplazisi n Hipersplenizm
n n Nötrofil sayısında artış+ sola kayma + toksik değişiklikler veya atipik lenfosit infeksiyon, inflamatuvar değişiklikler Anemi+ blast varlığı-lösemi, lenfoma
KEMİK İLİĞİ n n Tedaviye yanıtsız olgular İki veya üç hücre tipini de içeren değişiklikler olduğunda Aplastik anemi Lösemi
ANEMİLERDE TANISAL YAKLAŞIM MCV Düşük Fe eks Pb Zeh Talasemi Kr. Hast. Normal Retikülosit Yüksek Düşük Bilirubin Lökosit ve Trombosit sayısı Yüksek Normal Artmış Hemolitik Kanama İnfeksiyon Coombs testi (+) Eritosit dışı Otimmun hem anemi Rh, Abo uygunsuzluğu Yüksek Folat eks. B 12 Aplastik anemi Imm. hemolitik anemi KC hastalığı (- ) Eritrosit içi -Hb -Enzim -Mebra Eritrosit dışı -İdyopatik -İlaç, İnfeksiyon Normal Blackfan Diamond Geçici enitroblastopeni Düşük Malignite
İLERİ TESTLER Demir Eksikliği Anemisi Serum demiri B 12, folik asit eksikliği Herediter sferositoz Enzim eksikliği Hb defekti Demir bağlama kapasitesi Ferritin Serum B 12 ve folik asit seviyesi morfoloji, osmotik frajilite otohemoliz, enzim seviyesi Hb elektroforezi
n Demir Eksikliği, Thalassemi minör ve kronik Hastalık Anemisinde Laboratuvar Bulguları Fe eks Thalas taşıyıcı Kronik Hst MCV Düşük/ N Serum Fe Düşük N Düşük Fe bağlı kap. Artmış N Düşük Ferritin Düşük N Artmış Kİ de Fe yok Var